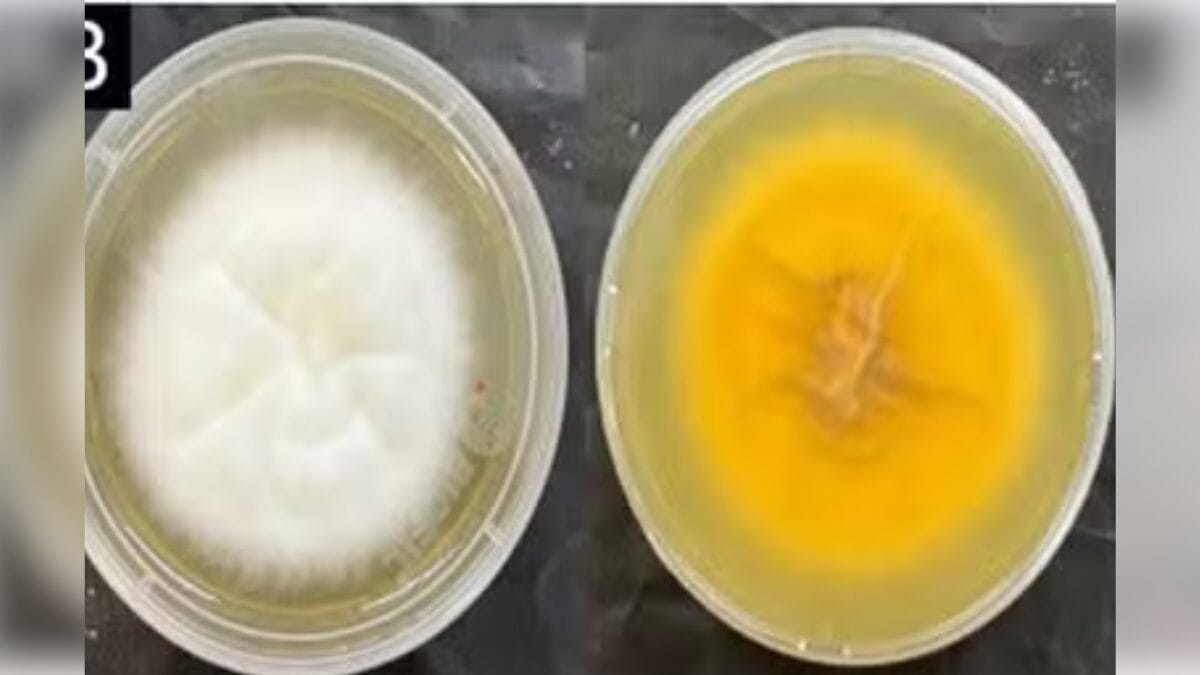

O primeiro caso de infecção pelo fungo Trichophyton indotineae, que apresenta resistência aos tratamentos médicos, foi registrado no Brasil. O caso ocorreu em Piracicaba, no interior de São Paulo. O paciente, de 40 anos, veio da Europa e apresentava vermelhidão na região dos glúteos. Com informações do g1.
Continua depois da publicidade
Clique aqui para receber as notícias do NSC Total pelo Canal do WhatsApp
Com poucos casos registrados até o momento, o primeiro relato do fungo foi feito na índia, mas a infecção já foi registrada na Europa e na Ásia. No Brasil, o primeiro registro foi publicado pela revista científica Anais Brasileiros de Dermatologia, em um atendimento feito pela dermatologista Renata Diniz.
O paciente é brasileiro e mora em Londres, na Inglaterra, mas também tinha realizado viagens para Áustria, Eslováquia, Hungria, Polônia, Escócia e Turquia. O diagnóstico em Piracicaba ocorreu quando ele veio visitar a família.
Na ocasião, o homem apresentava uma micose persistente na região dos glúteos, da perna, com manchas vermelhas que descamam e coçam, e que não respondiam ao tratamento realizado até então.
Continua depois da publicidade
“Logo na primeira consulta eu já estranhei, porque era um paciente jovem, com muitas lesões grandes, disseminadas, e que não tinha respondido a tratamentos fúngicos que a gente usa de forma corriqueira. Então, ele já acendeu um alerta, e aí optei por mudar o tratamento. Ele respondeu com o tratamento mas, logo que ele terminou de tratar, voltaram as lesões”, destaca a dermatologista Renata Diniz.
O diagnóstico do fungo foi feito após a especialista acionar o dermatologista John Verrinder Veasey, um dos autores da pesquisa e coordenador do Departamento de Micologia da Sociedade Brasileira de Dermatologia (SBD), que sugeriu a pesquisa pelo Trichophyton indotineae. O laboratório especializado do Instituto de Medicina Tropical (IMT) da Universidade de São Paulo (USP) confirmou a infecção.
Veja as fotos do fungo
Resistente a tratamentos e de alta transmissão
Segundo a médica, o fungo não apresenta riscos de morte aos humanos, mas ele possui alta resistência a tratamentos e facilidade na transmissão, que ocorre por contatos com outras pessoas ou com objetos.
Continua depois da publicidade
— Ele tem um impacto do ponto de vista social, de relações, pela transmissão. Porque tendo um fungo que não tem um tratamento efetivo garantido, existe esse perigo de transmitir para cada vez mais pessoas um fungo para o qual, por enquanto, não se tem tratamento — afirma a médica.
Em relação à prevenção, a profissional diz que são necessários cuidados com a higiene, como no uso de toalhas. Ela também garante a importância do diagnóstico precoce.
— Uma coisa é você estar dentro de casa, saber que está todo mundo ali saudável, mas não usar toalhas em locais públicos. Tem sempre um cuidado de onde você está em contato, áreas de maior risco. Fala-se muito de piscinas, sobre os cuidados de vestiário, que são ambientes úmidos, quentes, e que muitas pessoas circulam — afirma.
Leia mais
Chá de gengibre com cúrcuma: veja por que essa combinação é uma bomba de saúde
Preta Gil é internada novamente em hospital no Rio de Janeiro; entenda o motivo